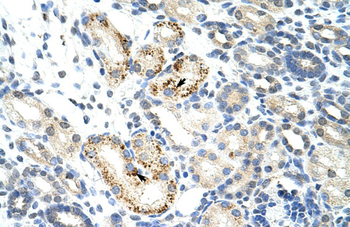
NOC4L Rabbit Polyclonal Antibody

You have no items in your shopping cart.
NOC4L Rabbit Polyclonal Antibody
Description
Research Area
Images & Validation
−| Tested Applications | ELISA, FC, ICC, IF, WB |
|---|---|
| Dilution Range | Western blot, 0.1-0.25 μg/ml, Human Immunocytochemistry/Immunofluorescence, 5 μg/ml, Human Flow Cytometry (Fixed), 1-3 μg/1x10^6 cells, Human ELISA, 0.1-0.5 μg/ml, - |
| Reactivity | Human |
Key Properties
−| Antibody Type | Primary Antibody |
|---|---|
| Host | Rabbit |
| Clonality | Polyclonal |
| Isotype | Rabbit IgG |
| Immunogen | E.coli-derived human NOC4L recombinant protein (Position: R17-R504). |
| Target | Nucleolar complex protein 4 homolog |
| Molecular Weight | 58 kDa |
| Purification | Immunogen affinity purified. |
| Conjugation | Unconjugated |
Storage & Handling
−| Storage | Maintain refrigerated at 2-8°C for up to 2 weeks. For long term storage store at -20°C in small aliquots to prevent freeze-thaw cycles. |
|---|---|
| Form/Appearance | Lyophilized |
| Buffer/Preservatives | Each vial contains 4 mg Trehalose, 0.9 mg NaCl, 0.2 mg Na2HPO4. |
| Concentration | Adding 0.2 ml of distilled water will yield a concentration of 500 μg/ml. |
| Expiration Date | 12 months from date of receipt. |
| Disclaimer | For research use only |
Alternative Names
−Similar Products
−NOC4L Rabbit Polyclonal Antibody [orb577862]
IHC, WB
Bovine, Equine, Guinea pig, Mouse, Porcine, Rat
Human
Rabbit
Polyclonal
Unconjugated
100 μlNOC4L Rabbit Polyclonal Antibody [orb577861]
WB
Bovine, Canine, Equine, Porcine, Rat
Human
Rabbit
Polyclonal
Unconjugated
100 μlNOC4L Rabbit Polyclonal Antibody [orb629343]
ELISA, WB
Human, Mouse, Rat
Rabbit
Polyclonal
Unconjugated
50 μg, 100 μgNOC4L Rabbit Polyclonal Antibody (HRP) [orb2124533]
IHC, WB
Bovine, Equine, Guinea pig, Human, Mouse, Porcine, Rat
Rabbit
Polyclonal
HRP
100 μl

Quality Guarantee
Explore bioreagents carefree to elevate your research. All our products are rigorously tested for performance. If a product does not perform as described on its datasheet, our scientific support team will provide expert troubleshooting, a prompt replacement, or a refund. For full details, please see our Terms & Conditions and Buying Guide. Contact us at [email protected].

Flow Cytometry analysis of 293T cells using anti-NOC4L antibody. Overlay histogram showing 293T cells (Blue line). To facilitate intracellular staining, cells were fixed with 4% paraformaldehyde and permeabilized with permeabilization buffer. The cells were blocked with 10% normal goat serum. And then incubated with rabbit anti-NOC4L Antibody (1 µg/1x10^6 cells) for 30 min at 20°C. DyLight®488 conjugated goat anti-rabbit IgG (5-10 µg/1x10^6 cells) was used as secondary antibody for 30 minutes at 20°C. Isotype control antibody (Green line) was rabbit IgG (1 µg/1x10^6) used under the same conditions. Unlabelled sample (Red line) was also used as a control.

IF analysis of NOC4L using anti-NOC4L antibody and anti-Beta Tubulin antibody. NOC4L was detected in immunocytochemical section of HELA cell. Enzyme antigen retrieval was performed using IHC enzyme antigen retrieval reagent for 15 mins. The cells were blocked with 10% goat serum. And then incubated with 5 µg/mL rabbit anti-NOC4L Antibody and mouse anti-Beta Tubulin antibody overnight at 4°C. Cy3 Conjugated Goat Anti-Rabbit IgG and DyLight®488 Conjugated Goat Anti-Mouse IgG were used as secondary antibody at 1:500 dilution and incubated for 30 minutes at 37°C. Visualize using a fluorescence microscope and filter sets appropriate for the label used.

Western blot analysis of NOC4L using anti-NOC4L antibody. Electrophoresis was performed on a 5-20% SDS-PAGE gel at 70V (Stacking gel) / 90V (Resolving gel) for 2-3 hours. The sample well of each lane was loaded with 30 ug of sample under reducing conditions. Lane 1: human Hela whole cell lysates, Lane 2: human Jurkat whole cell lysates, Lane 3: human 293T whole cell lysates, Lane 4: human A549 whole cell lysates. After electrophoresis, proteins were transferred to a nitrocellulose membrane at 150 mA for 50-90 minutes. Blocked the membrane with 5% non-fat milk/TBS for 1.5 hour at RT. The membrane was incubated with rabbit anti-NOC4L antigen affinity purified polyclonal antibody at 0.25 µg/mL overnight at 4°C, then washed with TBS-0.1% Tween 3 times with 5 minutes each and probed with a goat anti-rabbit IgG-HRP secondary antibody at a dilution of 1:5000 for 1.5 hour at RT. The signal is developed using an Enhanced Chemiluminescent detection (ECL) kit with Tanon 5200 system. A specific band was detected for NOC4L at approximately 58 kDa. The expected band size for NOC4L is at 58 kDa.
Quick Database Links
UniProt Details
−Documents Download
Request a Document
Protocol Information
NOC4L Rabbit Polyclonal Antibody (orb1743808)
Participating in our Biorbyt product reviews program enables you to support fellow scientists by sharing your firsthand experience with our products.
Login to Submit a Review